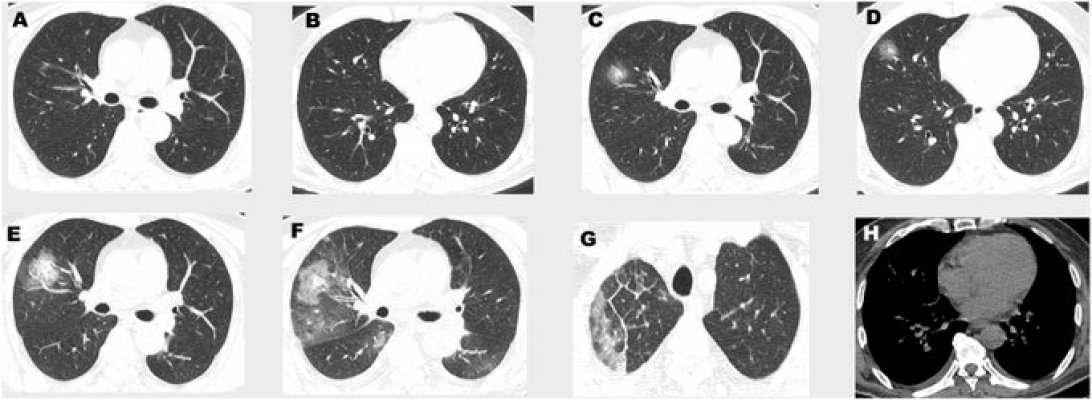
esw1rwjxsaenwja

"MORAMO DA BIRAMO KO ĆE UMRIJETI", DRAMATIČAN RAZGOVOR ITALIJANSKIH LJEKARA PROCURIO U JAVNOST: Važno je da ljudi shvate SVU OZBILJNOST!

Na italijanskim društvenim mrežama počela su da kruže dva dramatična audio snimka doktora iz Lombardije i iz Rima, koji se suočavaju sa velikom krizom u toj zemlji zbog epidemije koronavirusa.
U prvom dijelu snimka doktor iz Lombardije, epicentra virusa u Italiji, objašnjava kakva je situacija.
"Zatvorili su čitava odjeljenja, smanjili broj kreveta u pređašnjim odjeljenjima, stopirane su sve operacije, zatvorene su sve klinike kako bi svi ljekari mogli da dođu i pomognu u borbi protiv koronavirusa.
Dolaze svakog dana sve više, eksponencijalno. Broj kreveta na intenzivnoj njezi se utrostručio. Htjeli su da zaustave i naše kardio odjeljenje. Čak je i mreža za STEMI srčane pacijente zatvorena, sve se decentralizuje. Bolnica u Nigvardi je puna, ima oko 30 "kovida" na intenzivnoj njezi. Zbog ove situacije odlučuje se ko će se intubirati, a ko će umrijeti.
Za sada na kardiologiji nema oboljelih od korone, ali je virus veoma podmukao za identifikovanje. Za jednog pacijenta sam rekao da sigurno ima upalu pluća, sada ga testiraju i sigurno ima virus.

foto: EPA
Ne možeš ga prepoznati, a nemate pojma, ovoga nema u medijima, koliko mladih ima užasne upale pluća i potrebni su im aparati za disanje. To je nestvarno.
Doktori se više ni ne pregledaju, kažu - Ukoliko ste imali kontakt, ali bez simptoma, dođite na posao. Ukoliko imate simptome, odlučujete da li ćete da radite ili ćete ostati kod kuće.
Ovo je tragedija. Sada upošljavaju i sve nespecijalizovane diplomce sa Poliklinike. Na Poliklinici samo jedno od 4 krila nije za pacijente koronavirusa. Ima oko 50 upala pluća dnevno. Situacija je dramatična. Mnogo nam je važno da ljudi ovo razumiju", rekao je jedan doktor.
Druga doktorka koja se čuje na snimku, Martina, kardiolog sa odjeljenja intenzivne njege u Milanu, kaže da je situacija veoma ozbiljna jer je virus veoma zarazan.
"Neki nemaju simptome, neki dođu sa pregršt problema, ali takođe je istina da ljudi dolaze sa tzv. bilateralnom upalom pluća kada ne možete sami da dišete. Nemamo lijekova, antibiotici ne deluju, tako da im dajemo koktel lijekova koji se koriste protiv virusa poput AIDS, ali ne znamo da li to djeluje ili ne. Sve što možemo je da intubiramo pacijente, da mašina diše umjesto njih, odmorimo pluća i čekamo da imuni sistem pobijedi. Većinu smrtnih slučajeva čine stariji sa već postojećim zdravstvenim problemima, ali ima i mlađih, najmlađi na intenzivnoj njezi ima 38 godina. Nema respiratora za sve. Juče me je neko zvao da im damo jedan respirator, sad imamo samo dva. Ukoliko se pacijentu pogorša stanje, neće biti respiratora. Tako da moramo da odlučimo kome ćemo pomoći, prioritet su mladi i oni bez komorbiditeta. U Nigvardi ne intubiraju starije od 60, što je strašno. Situacija je veoma ozbiljna, veoma je zarazno - 14 dana možete proći bez simptoma, a zaraziti nevejrovatan broj ljudi.
Kako ne bismo imali masakr, treba da imamo što manji broj inficiranih. Ako su za 10.000 ljudi potrebni respiratori, a svi su zaraženi u isto vrijeme, to znači da će 7.000 ljudi umrijeti jer ih imamo samo 3.000. Cilj je da se uspori proces zaraze. Sve što možete da uradite je ono što se već priča - ostati kod kuće, nema izlaska na javna mjesta, nema šetnji, škole zatvorene, nema fudbala uveče, nema večernjih izlazaka, izbjegavajte kontakt sa drugima što više možete, perite ruke. Virus se zadržava na površini oko 30-40 minuta, jedini način da se očisti površina je da se pranje varikinom i ostavljanje izbjeljivača da odstoji 30 minuta.
Za 10 dana je došlo do nevjerovatne eskalacije, Lombardija se prva srušila iako ima najbolji zdravstveni sistem, ni ne pomišljam šta može da se desi u drugim regionima.
Kada je riječ o djeci, nema strašnih slučajeva, virus je manje agresivan kod njih nego kod odraslih, ali su užasni prenosioci, zato što nemaju simptome, a to se onda proširi na babe i dede i ubije ih. Tako da kontakt djece i starijih treba izbjegavati.
Martina zaključuje da ne treba paničiti, ali ni potcjenjivati ovaj virus.
"Ostanite kod kuće i ne nalazite se sa bilo kim", rekla je.
KUĆNI TEST OD 10 SEKUNDI: Uradite ovo svako jutro i otkrijte da li IMATE VIRUS!
Broj jedan za zanimljivosti - Novi.ba. Vaš izvor informacija.